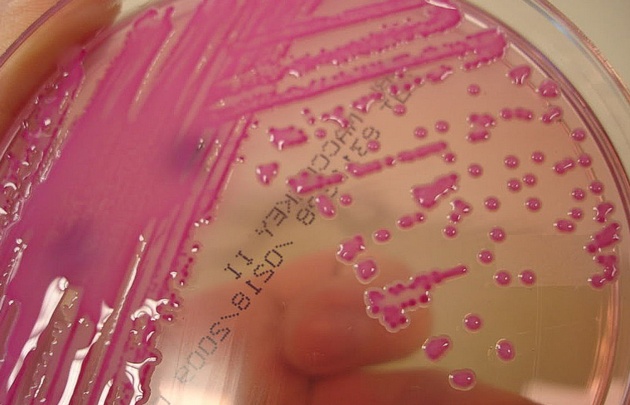
Klebsiella, bacteria intrahospitalaria.

La Klebsiella, la bacteria en el Hospital de Urgencias
El presidente de la Sociedad Argentina de Infectología Lautaro de Vedia explicó a Cadena 3 que la bacteria "a veces los pacientes la portan en los intestinos y puede generar enfermedades".
14/10/2017 | 10:37Redacción Cadena 3
El Hospital de Urgencias le exige a todos los familiares de pacientes portadores de la bacteria intrahospitalaria Klebsiella Kpc que usen barbijo, gorro y bata ara ingresar al nosocomio.
El presidente de la Sociedad Argentina de Infectología Lautaro de Vedia (M.P. 70640) explicó a Cadena 3 que se trata de una bacteria que desarrolló "mecanismos para hacerse resistentes a los antibióticos usuales".
"A veces los pacientes la portan en intestino, se puede trasmitir de un paciente y pueden generar enfermedades", dijo.
Indicó que "las opciones terapéuticas son escasas porque (las bacterias) son resistentes a muchos antibióticos".
Advirtió que "en general puede causar enfermedades graves y afecta a internados mayormente en terapia intensiva, con factores ya predisponentes".
Medicamentos fuertes
De Vedia señaló que "hay muchas causas" por las que surgen las bacterias intrahospitalarias.
"Empezamos desde los propios médicos que usamos exageradamente los antibióticos y en muchos casos injustificadamente o muchos días", indicó.
"También se suma la comunidad que se automedica lo que genera en el ambiente, en las bacterias -que son seres vivos- mecanismos genéticos que las hacen resistentes", añadió.
Llamó a que los médicos receten antibióticos justificadamente, "con más precisión".
Evitar hospitales para casos menores
De Vedia dijo que "los ideal es que la gente se atienda en centros chicos y periféricos" y que los "los hospitales sean para una etapa avanzada".
Apuntó que la bacteria se propaga "más fácilmente" en ambientes hospitalarios donde "hay pacientes con catéter, suero, respirador y en esa situación".
Entrevista de Una Mañana Para Todos.